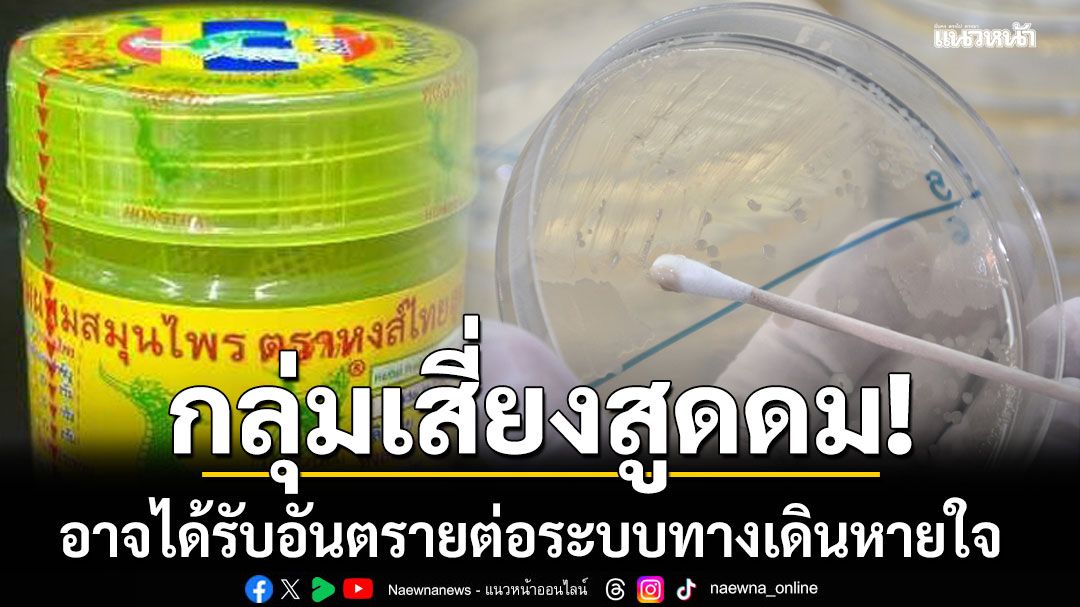
กรมวิทย์ฯ เปิดผลตรวจยาดมสมุนไพร'หงส์ไทย' กลุ่มเสี่ยงอาจอันตราย

วันพฤหัสบดี ที่ 14 พฤษภาคม พ.ศ. 2569
วันพฤหัสบดี ที่ 14 พฤษภาคม พ.ศ. 2569
 วันพฤหัสบดี ที่ 14 พฤษภาคม พ.ศ. 2569
วันพฤหัสบดี ที่ 14 พฤษภาคม พ.ศ. 2569
วันที่ 29 ตุลาคม 2568 ดร.นพ.สราวุฒิ บุญสุข อธิบดีกรมวิทยาศาสตร์การแพทย์ เปิดเผย กรณีที่สำนักงานคณะกรรมการอาหารและยา (อย.) ได้เก็บตัวอย่างยาดมสมุนไพร ตราหงส์ไทย เลขทะเบียน G 309/62 รุ่นการผลิต 000332 ว่า กรมวิทยาศาสตร์การแพทย์ ได้รับตัวอย่างยาดมสมุนไพร ตราหงส์ไทย สูตร 2 จาก อย. จำนวน 2 ครั้ง ครั้งที่ 1 ส่งตรวจเดือนมิถุนายน รายงานผลกรกฎาคม ครั้งที่ 2 ส่งตรวจเดือนสิงหาคม รายงานผลกันยายน ผลตรวจพบผิดมาตรฐานในหัวข้อจำนวนเชื้อจุลินทรีย์ที่เจริญเติบโตในอากาศทั้งหมด จำนวนรวมของยีสต์และรา และพบการปนเปื้อนเชื้อคลอสตริเดียม (Clostridium spp.) ซึ่งจากการตรวจยืนยัน พบเป็น เชื้อคลอสตริเดียม เพอร์ฟริงเจนส์ (Clostridium perfringens)
ดร.นพ.สราวุฒิ กล่าวต่ออีกว่า สำหรับวิธีการตรวจนั้น กรมวิทยาศาสตร์การแพทย์ โดย สำนักยาและวัตถุเสพติด ดำเนินการตรวจโดยวิธีมาตรฐานตำรายาบริติชฟาร์มาโคเปีย (British Pharmacopoeia) และตำรามาตรฐานยาสมุนไพรไทย (Thai Herbal Pharmacopoeia) และใช้ข้อกำหนดเกณฑ์มาตรฐานตามประกาศกระทรวงสาธารณสุข เรื่อง เกณฑ์มาตรฐาน ค่าความบริสุทธิ์ หรือคุณลักษณะอื่นอันมีความสำคัญต่อคุณภาพ สำหรับตำรับผลิตภัณฑ์สมุนไพรที่ขึ้นทะเบียน แจ้งรายละเอียด หรือจดแจ้ง พ.ศ.2564
การตรวจการปนเปื้อนเชื้อจุลินทรีย์ ประกอบด้วย
1. จำนวนเชื้อจุลินทรีย์ที่เจริญเติบโตในอากาศทั้งหมด ต้องไม่เกิน 200 โคโลนี/กรัม
2. จำนวนรวมของยีสต์และรา ต้องไม่เกิน 20 โคโลนี/กรัม
3. จุลินทรีย์เฉพาะ ต้องไม่พบเชื้อจุลินทรีย์สแตปฟิโลค็อคคัส ออเรียส เชื้อซูโดโมแนสแอรูจิโนซา และเชื้อคลอสตริเดียม
.jpg)
โดยวิธีการตรวจหาจำนวนเชื้อจุลินทรีย์ที่เจริญเติบโตในอากาศทั้งหมด และจำนวนรวมของยีสต์และรา ใช้วิธี Plate count ซึ่งเป็นการเพาะเลี้ยงเชื้อที่ปนเปื้อนในตัวอย่างบนจานเพาะเลี้ยงเชื้อ แล้วนับจำนวนเชื้อจุลินทรีย์ที่เจริญบนจานอาหารเลี้ยงเชื้อ
ส่วนการตรวจหาเชื้อจุลินทรีย์เฉพาะ ใช้วิธีการเพิ่มจำนวนเชื้อในอาหารเลี้ยงเชื้อเหลว และแยกด้วยอาหารเลี้ยงเชื้อเฉพาะสำหรับเชื้อแต่ละชนิด ทำการย้อมสีและดูลักษณะภาพใต้กล้องจุลทรรศน์
อธิบดีกรมวิทยาศาสตร์การแพทย์ กล่าวต่ออีกว่า ในปีงบประมาณ พ.ศ.2568 มีผลิตภัณฑ์ยาดมส่งตรวจที่สำนักยาและวัตถุเสพติด กรมวิทยาศาสตร์การแพทย์ จำนวน 54 ตัวอย่าง พบผิดมาตรฐาน 39 ตัวอย่าง ซึ่งส่วนใหญ่จะผิดมาตรฐานในเรื่อง จำนวนรวมของจุลินทรีย์ที่เจริญเติบโตโดยใช้อากาศ จำนวนรวมของยีสต์และรา และเชื้อคลอสตริเดียม (Clostridium spp.) จากการตรวจยืนยัน พบเป็นเชื้อคลอสตริเดียมเพอร์ฟริงเจนส์ ซึ่งกรมได้แจ้งหน่วยงานที่เกี่ยวข้องดำเนินการต่อไปแล้ว
“เชื้อคลอสตริเดียม เพอร์ฟริงเจนส์ สามารถพบได้ทั่วไปในดิน เป็นเชื้อที่เจริญเติบโตได้ในสภาวะไร้ออกซิเจน ทั้งนี้ผู้มีร่างกายอ่อนแอ ภูมิคุ้มกันต่ำ หรือผู้สูงอายุ หากสูดดมอาจได้รับอันตรายจากสปอร์ของเชื้อราและเชื้อคลอสตริเดียม เพอร์ฟริงเจนส์ ซึ่งอาจมีผลกระทบต่อระบบทางเดินหายใจ เช่น หายใจลำบาก มีเสียงหวีดและอาการไอ ปวดปากและลำคอ นอกจากนี้อาจมีเลือดปนในน้ำลายและเสมหะได้
ดังนั้นผู้ผลิตควรมีการกำจัดหรือลดปริมาณเชื้อจุลินทรีย์ก่อนนำมาผลิตเป็นผลิตภัณฑ์สมุนไพร เช่น การล้าง อบ การฉายรังสี เพื่อความมั่นใจกรมวิทยาศาสตร์การแพทย์พร้อมสนับสนุนกลุ่มผู้ผลิตรายย่อยในการตรวจสอบคุณภาพก่อนจดทะเบียน เพื่อให้ได้ผลิตภัณฑ์ที่มีคุณภาพและปลอดภัยกับผู้บริโภค” ดร.นพ.สราวุฒิ กล่าวทิ้งท้าย
โปรดอ่านก่อนแสดงความคิดเห็น
1.กรุณาใช้ถ้อยคำที่ สุภาพ เหมาะสม ไม่ใช้ ถ้อยคำหยาบคาย ดูหมิ่น ส่อเสียด ให้ร้ายผู้อื่น สร้างความแตกแยกในสังคม งดการใช้ถ้อยคำที่ดูหมิ่นหรือยุยงให้เกลียดชังสถาบันชาติ ศาสนา พระมหากษัตริย์
2.หากพบข้อความที่ไม่เหมาะสม สามารถแจ้งได้ที่อีเมล์ online@naewna.com โดยทีมงานและผู้จัดทำเว็บไซด์ www.naewna.com ขอสงวนสิทธิ์ในการลบความคิดเห็นที่พิจารณาแล้วว่าไม่เหมาะสม โดยไม่ต้องชี้แจงเหตุผลใดๆ ทุกกรณี
3.ขอบเขตความรับผิดชอบของทีมงานและผู้ดำเนินการจัดทำเว็บไซด์ อยู่ที่เนื้อหาข่าวสารที่นำเสนอเท่านั้น หากมีข้อความหรือความคิดเห็นใดที่ขัดต่อข้อ 1 ถือว่าเป็นกระทำนอกเหนือเจตนาของทีมงานและผู้ดำเนินการจัดทำเว็บไซด์ และไม่เป็นเหตุอันต้องรับผิดทางกฎหมายในทุกกรณี